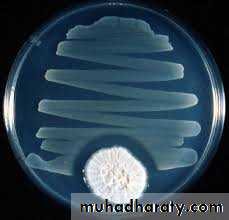

History
• Early 1900s: Paul Erlich -Concepts of Chemotherapy and selective toxicitySalvarsan for Syphilis
• Fleming (1928) and Florey and Chain (1939) – penicillin
3. 1935: Gehard Domagk - sulfa drugs
4. 1944: Waksman - streptomycin
Chemotherapy: is the use of chemical agents (either synthetic or natural) to destroy infective agents (microorganisms’ i.e bacteria, fungus and viruses, protozoa, and helminthes) and to inhibit the growth of malignant or cancerous cells. Characterised by selective toxicity depends on the existence of exploitable biochemical difference between the parasite and the host cell. Antimicrrobials: are chemical agents (synthetic/natural) used for the treatment of infections by suppressing or destroying the causative microorganisms (bacteria, mycobacteria, fungi, protozoa, or viruses). Antibiotics: are substances produced by various species of microorganisms (bacteria, fungi, actinomycetes) that suppress the growth of other microorganisms.
Classification of antibacterial drugs
1-Bacteriostatic agents: Agents that inhibit the growth of the microorganisms by producing reversible changes. This delay in the growth will give the immune system the chance to get rid of the microorganism.
Bactericidal agents: Agents that kill the microorganism.
(Being a bactericidal or a bacteriostatic agent depends on the mechanism of action of the antibacterial agent and on its concentration.)
2- SpectrumNarrow spectrum: The range of activity for agents that kill the micro-organism is small. It affects 1-2 classes of microorganisms only. For example, Penicillin-G affects G+ve organisms and Neisseriae. Broad spectrum: The range of activity extends to many micro-organisms. For example, Tetracyclines depress G+ve, Gve, Rickettsiae and Chlamydiae. Separation between narrow and broad spectrum activity is not clear due to the emergence of many resistant strains due to the overuse of these antibiotics. Broad spectrum antibiotics should be restricted to treatment of specific infections caused by a few organisms or even a single species of organism. The property of broad specification should not be confused with a free license for broad-nonspecific use.
Classification according to chemical structure
Beta-lactam ( penicillins and cephalosporins)Aminoglycosides
Tetracyclins
Chloramphenicol
Macrolids
Quinolines
sulfanomides
Classification according to mode of action
Mechanisms of antimicrobial drug action:Inhibition of cell wall synthesis ( beta-lactams)
Beta lactams contain β- ring which is an analogue of D-alanyl-D-alanine on peptide side chain of peptidoglycan à inhibits transpeptidase from crosslinking Peptidoglycan + binds penicillin binding proteins à activation of autolysins
Bacitracin, Vancomycin, Cycloserine: Block peptidoglycan synthesis
2. Cell membrane function inhibitors (polypeptides): Polymxin B: interact with phospholipids to increase permeability and decrease osmotic integrity and leakage on intracellular components
3. Inhibition of protein synthesis ( tetracyclins, aminoglycosides, macrolids, chloramphenicol)
a-Tetracyclins: reversible binding to the 30s subunit of ribosome ànd inhibit binding of aminoacyl tRNA to ribosome à inhibition of protein synthesis
b-Aminoglycosides: irreversible binding to the 30s subunit of ribosome and inhibit protein synthesis and causes misreading of mRNA
c-Macrolids: reversibly binds 50s subunit of the ribosome à inhibits translocation during protein synthesis
d-Chloramphenicol: binds to 50s subunit of the ribosome à inhibits transpeptidation during protein synthesis
4. Inhibition of nucleic acid synthesis ( quinolines, rifampicin) a- Quinolines: inhibits DNA gyrase à inhibition of DNA replication. b- Rifampicin: inhibits DNA- dependent RNA polymerase à inhibition of RNA synthesis
5. Antimetabolites ( sulfonamides, trimethoprim) a- sulfonamides: competes with p-aminobenzoic acid for binding to the enzyme dihydropteroate synthetase à no folic acid synthesis à no nitrogenous base synthesis b-Trimethoprim: dihydrofolate reductase inhibitor
Using and avoiding antibacterial drugs Antibacterials are valuable drugs if used appropriately. They are very effective in treating infections if used in appropriate doses, at appropriate intervals and for the appropriate period of time against sensitive microorganisms.Anti-infective agents should be used only when:a. A significant infection has been diagnosed or is strongly suspected.b. An established indication for prophylactic therapy exists.Abuse of these agents causes superinfections, cross-sensitivity and cross resistance, resulting in inappropriate treatment and in consequent adverse reaction in addition to wastage of money.They should not be used in the following cases:1. To treat all infections (e.g. viral infections or nonspecific inflammation).2. For minor infections (e.g. superficial bruises).3. For cases need surgical opening and draining such as abscess Superinfection (suprainfection): Is the appearance of both microbiological and clinical evidence of a new infection with pathogenic microorganisms or fungi not sensitive to the used drugs during antimicrobial treatment of a primary disease. The body's natural resistance is compromised, making it more susceptible to secondary infections by more dangerous strains.
Bacterial resistance:Antimicrobial agents are loosing their effectiveness because of the spread of drugresistantstrains. Therefore, there might come a time when such agents are no longer useful to combat diseases. Mechanisms of resistance to antibiotics1. Production of enzymes that inactivate the drug (eg. β -lactamase, which inactivates beta lactam antibiotics; acetyl transferases, which inactivate chloramphenicol; kinases and other enzymes, which inactivate aminoglycosides.2. Alteration of the drug-binding site: this occurs with penicillins, aminoglycosides and erythromycin.3. Reduction of drug uptake by the bacterium: eg. Tetracyclines4. Alteration of enzymes: eg. Dihydrofolate reductase becomes insensitive to trimethoprim. Reasons for antibiotic resistance1. Misuse of antibiotics selects for resistance mutants. Misuse includes:a. Using outdated, weakened antibioticsb. Using antibiotics for viral infection like common cold and other inappropriate conditionsc. Use of antibiotics in animal feedd. Failure to complete the prescribed regiment
Selecting anti-infective agent:a. The spectrum of activity of the antiinfective agent: It should be active againstthe causative pathogen. This can be known by carrying the susceptibility tests or by agood clinical experience in treating a given syndrome that will help in suggesting apotential effective agent.b. Patient factors: These factors play a very important role in the selection of a specific anti-infective agent, determination of the appropriate drug dosage and route of administration,...etc. Those factors include: 1. History of drug allergy or adversereactions. Anaphylaxis or reactions due to immunoglobulin E (IgE) may be lifethreatening when taking penicillins. 2. Age: A drug’s pharmacokinetic properties vary widely in patients of different age groups. 3. Underlying disease: -A pre-existing kidney and liver disease, CNS disorder. Neuromuscular disorders. 4. Immunological status: Patients with impaired immune system require a bactericidal agent rather than a bacteriostatic one. 5. Pregnancy and lactation. 6. Genetic traits. Combination therapy in special situations- Extend the antimicrobial spectrum especially in Initial empiric therapy-Mixed infections or severe infections: -To prevent the emergence of resistance:Duration of therapy:Acute cases: Treatment of acute uncomplicated infections generally should continue until the patient has been a febrile and asymptomatic for at least 72 hours (minimum 5 days in most cases). Other cases as in Strep. throat (Streptococcal pharyngitis) should be treated for 7-10 days. Some infections require a proof of eradication by culture. Chronic cases: Treatment of chronic infections (e.g., endocarditis, osteomyelitis) may require a longer duration (4 to 6weeks), with a follow-up culture analysis afterwards.
Cell wall inhibitors:Beta lactams (penicillins and cephalosporins)
Penicillins:Chemical structure: Three components: A thiazolidine ring, the β-lactam ring (responsible for their activity), and a side chain (determines in large part to antibacterial spectrum and pharmacologic properties of a particular penicillin)
Classification of PenicillinsNatural PenicillinsPenicillin G (benzylpenicillin) Penicillin G benzathine, phenoxymethyl penicillin) Penicillinase-Resistant PenicillinsMethicillin, Cloxacillin, Oxacillin, Nafcillin, Dicloxacillin Extended-Spectrum PenicillinsAmpicillin , Amoxicillin, Anti-Pseudomonal Pencillins Carbenicillin, Ticarcillin, Piperacillin ß-Lactamase CombinationsAmpicillin- Cloxacillin Amoxillin-clavulanic acid, Ampicillin-sulbactam, Ticarcillin-clavulanic acid
Natural penicillins: Benzylpenicillin & Phenoxymethyl penicillinThese two are known as the natural penicillins. They are the first two penicillins that were discovered and are still in use. Natural penicillins are narrow spectrum antibiotics and are only active against facultative gram-positive cocci, rods and gram-negative cocci. Severalanaerobic gram-negative rods are sensitive to penicillin, with the notable exception ofBacteroides fragilis. Benzyl penicillin is the drug of choice in streptococcal, pneumococcal, gonococcal, and eningococcal infections. It is also used in anthrax, diphtheria, gas gangrene, leptospirosis, syphilis, tetanus, yaws, and in the treatment of lyme disease in children. It is inactivated by the gastric fluids, and absorption from the gut is low; therefore it is given by injection.In addition to the use of Pen. G as sodium or potassium salts (soluble Pen. G), it is also available in two other salts that are commonly used. They are: a- Procaine penicillin: a sparingly soluble salt of benzylpenicillin. It is used in intramusculardepot preparations that provide therapeutic tissue concentrations for up to 24 hrs. It is the preferred choice for the treatment of syphilis, but neurosyphilis requires special consideration.b- Benzathine penicillin: a benzylpenicillin salt with a very low solubility, giving a prolonged action after intramuscular injection. Its duration of action is 20 days. Phenoxymethyl penicillin (Pen. V) Has a similar antibacterial spectrum as Pen. G, but it is less active. It is gastric acid stableso it is suitable for oral administration. It should not be used for serious infections because absorption can be unpredictable and plasma concentrations are variable.
Indications:Benzylpenicillin mainly indicated for the treatment for: throat infections otitis media,streptococcal endocarditis meningococcal and pneumococcal meningitis (if caused by susceptible microorganism) prophylactic agent after limb amputation. Also it is used in combination with other agents if more than one organism are suspected. Phenoxymethyl penicillin is indicated principally for respiratory tract infections in children, for Streptococcal tonsillitis and for continuing treatment after one or more injections of Pen. G when clinical response has begun. It should not be used for meningococcal or gonococcal infections.It is used prophylactically against rheumatic fever following streptococcal infections.Contraindications:They are contraindicated in the case of hypersensitivity to any of the penicillins or cephalosporins. Procaine penicillin is also contraindicated in the case of hypersensitivityto procaine or any other “caine type” local anesthetic.
• Penicillinase resistance penicillins (Antistaphylococcal penicillins)
• Cloxacillin, dicloxacillin, flucloxacillin and methicillin• Most staphylococci are now resistant to benzylpenicillin because they produce penicillinases.
• Cloxacillin and flucloxacillin are not affected by such enzymes, so they are effective in infections caused by penicillin resistant staphylococci, but they are less potent than Pen. G against penicillin sensitive microorganisms. and generally ineffective against G-ve bacteria and methicillin resistant staphylococci.
• The only difference between cloxacillin and flucloxacillin is that flucloxacillin has a
• higher bioavailability than cloxacillin after oral administration.
• Another two examples.
Methicillin is toxic and didn’t used medicinally
These drugs used in combination with ampicillin: ampicillin with cloxacillin or flucloxacillin and amoxicillin with cloxacillin.
• Cloxacillin: prepared as capsules and suspension. Flucloxacillin: Not available in a separate
• formulation, but as combination with ampicilin in capsules.
• Indication:
• Cloxacillin and flucloxacillin are indicated for the treatment of infections caused by
• penicillinase producing Staphylococci. Methicillin is toxic and not used medicinally.
Extended-Spectrum Penicillins also called (aminopenicillins): including ampicillin, amoxicillin and (bacampicillin and pivampicillin), which are esters of ampicillin.Aminopenicillins are active against some G+ve and G-ve organisms but inactivated by penicillinases, including those produced by Staphylococcus aureus, and by common G-ve bacilli such as Escherichia coli.The majority of Staphylococci, 50% of E. coli strains and 15% of Haemophilus influenzae strains are now resistant.Amoxicillin is a derivative of ampicillin that differs only by one hydroxyl group. Unlike ampicillin it can be given 3 times daily without regard to food. Ampicilline is given 4 times daily and its absorption affected by the presence of food in the stomach, so it should be taken one hour before or two hours after the meal).
Indication:They are principally indicated for the treatment of chronic bronchitis and mild ear infections, both of which are usually due to Streptococcus pneumoniae and Haemophilus influenzae. They are also indicated for: urinary-tract infections, otitis media, sinusitis, chronic bronchitis,invasive salmonellosis, and gonorrhea.Amoxicillin is also used for typhoid fever and endocarditis prophylaxis. Antipseudomonals include both carboxypenicillins (carbenicillin and ticarcillin) and ureidopenicillins (piperacillin, azlocillin, and mezlocillin). Antipseudomonal penicillins are similar to the aminopenicillins in structure but have either a carboxyl group or urea group instead of the amine.The major advantage of carboxypenicillins is their activity against Pseudomonas aeruginosa (one of the major pathogens responsible for nosocomial pneumonia) and certain indole-positive Proteus species that are resistant to aminopenicillins. Ticarcillin is stronger against P. aeruginosa and Enterobacter species than carbenicillin.Against anaerobes and Gram-positive organisms, carboxypenicillins generally have the same spectrum of activity as penicillin G. However, they are substantially weaker in comparison with penicillin G.Ureidopenicillins have greater activity against P. aeruginosa compared to carbenicillin and ticarcillin. Piperacillin is the most potent of the extended-spectrum penicillins against Pseudomonas. The spectrum of piperacillin and mezlocillin is extended to include Klebsiella, Enterobacter, Citrobacter.All antipseudomonals are destroyed by β-lactamases.The extended-spectrum penicillins are not used in the treatment of infections caused by Gram-positive bacteria because penicillin G and aminopenicillins are more potent against these organisms. Antipseudomonals penicillins may be used in combination with Aminoglycosides.
Note: The natural penicillins was originally used as units. International Unite= 0.6 microgram (0.0006 milligram) of penicillin ( 1 mg = 1670 IU) . Synthetic and semisynthetic penicillins in mg ………. Side effects of Penicillins:- Hypersensitivity and anaphylactic shock Hypersensitivity is one of the most important adverse reactions to penicillins. The frequency of allergic reactions to all penicillins ranges from 0.7% to 10%. The manifestations of penicillin allergy include maculopapular or morbilliform rash, fever, urticaria, exfoliative dermatitis, swelling of the throat, difficulty breathing, eosinophilia, serum sickness, Stevens-Johnson syndrome, and anaphylactic shock (0.004% to 0.015%)- Pain in injection- GI: diarrhea, nausea, vomiting, pseudo membranous colitis (rare).-CNS: convulsive seizures.-Skin: pruritus, urticaria, or other skin eruptions.-Hematological: hemolytic anemia, thrombocytopenia, purpura, eosinophilia, leukopenia, agranulocytosis.-Others: superinfections
First generationCefazolin IM, IV, Cephalothin IM, IV,Cephapirin IM, IV, Cefadroxil IV, PO Cephalexin PO, Cephradine PO activity1. Staph. aureus - excellent activity against b-lactamase-producing strainsNot effective against methicillin-resistant Staph. aureus & epidermidis2. Streptococci - excellent activity versus Streptococcus sp. Not effective against penicillin-resistant Strep. pneumoniae3. Other Gm + bacteria - excellent activity except for Enterococcus sp.4. Moderate activity against gram negative bacteria. Susceptible organisms include: E. coli, Proteus mirabilis Indole + Proteus sp. (many strains resistant) , Haemophilus influenzae (some strains resistant), Neisseria sp. (some gonococci resistant)Indication1. Upper respiratory tract infections due to Staph. and Strep.2. Lower respiratory tract infections due to susceptible bacteria e.g. Strep. pneumoniae in penicillin-allergic patient 3. Uncomplicated urinary tract infections (Cephalexin)4. Surgical prophylaxis for orthopedic and cardiovascular operations (cefazolin preferred because of longer half-life)5. Staphylococcal infections of skin and skin structure
Second GenerationCefuroxime IM, IV Cefuroxime axetil PO Cefamandole IM, IV Cefaclor PO Cefoxitin IM, IV Cefdinir PO Cefonicid IM, IV Cefprozil PO Cefotetan IM, IV Cefmetazole IV Activity1-Expanded activity against gram negative bacilli. Still have excellent activity against gram positive (Staph. and Strep.) bacteria. Activity for Gram negative bacteria Neisseria sp. (some gonococci resistant) H. influenzae (including some ampicillin-resistant strains)Moraxella catarrhalis (some resistance esp. to cefaclor), E. coli, Proteus mirabilis, Indole + Proteus (some strains resistant) Morganella morganii (some strains resistant), Klebsiella pneumonia, Serratia sp. (many strains resistant) 2-Anaerobic infections - (Cefoxitin & Cefotetan only) moderate activity against Bacteroides fragilis group. Good activity for other Bacteroides sp., Peptostreptococcus, Fusobacterium, Clostridium sp.Indications1. Community-acquired pneumonia - Cefuroxime is widely used for empiric therapy. 2. Skin and soft tissue infection3. Urinary tract infections4. Upper respiratory tract infections (otitis media, sinusitis). 5. Mixed aerobic & anaerobic infections 6. Surgical prophylaxis - Cefoxitin or cefotetan are widely used in cases where mixed aerobic & anaerobic infections may occur, esp. intra-abdominal, colorectal, and gynecologic operations. For cardiovascular and orthopedic procedures, cefuroxime and others may be used, but cefazolin is cheaper and appears to work well.
Third GenerationCefotaxime IM, IV Cefixime PO Ceftizoxime IM, IV Ceftibuten PO Ceftriaxone IM, IV Cefpodoxime axetil PO Ceftazidime IM, IV Cefoperazone IM, IVActivity Prototype drugs are Cefotaxime (IV) and Cefixime (oral). Ceftazidime (for Ps aeruginosa1-Further expansion of Gm negative spectrum to include E. Coli Proteus mirabilis (indole –) Proteus vulgaris (indole +)Klebsiella pneumonia Morganella morganii,Providencia retgerri, Citrobacter freundii, Serratia marcescens, Pseudomonas aeruginosa, (Ceftazidime) Enterobacter Stenotrophomonas maltophilia (Cefoperazone & Ceftazidime only) Acinetobacter 2-In general, activity toward Gm + bacteria is reduced Indications: 1. Gram negative septicemia & other serious Gm – infections2. Pseudomonas aeruginosa infections (Ceftazidime - 90% effective)3. Gram negative meningitis - Cefotaxime, Ceftriaxone, Cefepime. For empiric therapy add vancomycin ± rifampin to cover resistant Strep. pneumoniae4. Gonorrhea - Single shot of Ceftriaxone is drug of choice. Oral cefixime and ceftibuten are also OK.5. Complicated urinary tract infections, pyelonephritis6. Osteomyelitis - Ceftriaxone in home health care situations7. Lyme disease - ceftriaxone in home health care situations
Fourth generationcefepime IM, IVActivity -With similar activity against gram-positive organisms as first-generation cephalosporins.-Bu they are more active against G –ve and have a greater resistance to beta-lactamases than the third generation cephalosporins. Indications: 1-Pneumonia: Treatment of moderate-to-severe pneumonia 2-Febrile Neutropenia: Empiric therapy in febrile neutropenic patients. 3-Urinary Tract Infections. 4-Treatment of uncomplicated skin and skin structure infections. 5-Treatment of complicated intra-abdominal infections; use in combination with metronidazole Fifth generationCeftaroline IV Activity -Enhanced coverage of G+ve organisms: MRSA, S. pneumonia, and E. faecalis … -Similar gram negative coverage to third- and fourth-generation agents , does not cover Pseudomonas, limited anti-anaerobes activity.Indications: 1-Community-acquired bacterial pneumonia 2-Indicated for acute bacterial skin and skin structure infections, including MRSA
Pharmacokinetics: Cephalexin, cephradine, cefaclor, cephadroxil, cefuroxime axetil and cefixime are absorbed after oral administration and can be given orally. Most of the remaining cephalosporins are given parenterally. Cefixime is the only third generation cephalosporin available in oral dosage form. They are well distributed in the body. Adequate CSF concentrations are mainly achieved with third generation cephalosporins. Cephalosporins cross the placenta and they are found in higher concentration in synovial fluid and pericardial fluid. Cephalosporins are variably bound to plasma proteins, cefazolin is maximally bound (85%). They are mainly excreted in urine by glomerular filtration and tubular secretion. Probenecid decreases the tubular secretion and increase plasma level of cephalosporins. Dose adjustment is necessary in chronic renal failure. Cephalothin, cephapirin and cefotaxime are metabolized and their metabolites are excreted in urine. Cephoperazone and ceftriaxone are mainly excreted in bile, therefore can safely be given in CRF without dosage adjustments.
Side effects of cephalosporins: Hypersensitivity reactions to cepalosporins are the most common side effects, reaction appear to be identical to those caused by penicillin. More commonly maculopapular rash develops, usually after several days of therapy immediate reactions such as anaphylaxis, bronchospasm and urticaria are also observed. There is cross reactivity between penicillin and cephalosporins due to structural resemblance. Cephalosporins should be avoided in patients allergic to penicillin. Cephalosporins may produce nephrotoxicity, that is more common with cephaloridine (it is not used now a days). High dose of cephalothin produces renal tubular necrosis. Risk of nephrotoxicity is increased when cephalosporins are administered with other potential nephrotoxic agents (Aminoglycosides and Vancomycin). Diarrhea occurs frequently with cefoperazone because of greater biliary excretion. Pain and local irritation occurs after I/M injection. Some cephalosporins like cefamandole, moxalactam, cefoperazone, cefotetan frequently produce hypoprothrombinemia & bleeding disorders that can be prevented by administration of vitamin K. Cefamandole, cefoperazone, cefotetan and moxalactam can also cause severe disulfiram like reaction. Alcohol and alcohol containing medication must be avoided. Superinfections are observed mainly with second and third generation cephalosporins. Thrombophlebitis is observed after I/V injections
β-lactamase Inhibition 1. Sulbactam (ampicillin-sulbactam). 2. Clavulanic acid (amoxicillin-clavulanate, Augmentin; ticarcillin-clavulanate, Timentin). 3. Tazobactam (pipercillin-tazobactam, Zosyn). MonobactamsAztreonamAztreonam- a monocyclic β−lactam relatively resistant to β−lactamases. Spectrum similar to gentamycin. Active against Gram negative rods and resist β-lactamase. It is effective in treating Gram-negative urinary tract infections, lower respiratory tract, skin, intraabdominal, gynecologic infections and septicemia.It is administered either IV or IM.It is excreted in the urine. Has a low immunogenic potential. A safe alternative in patients allergic to penicillins and cephalosporins.Carbapenems:Carbapenems are synthetic β-lactams. Imipenem, meropenem and ertapenem are the available drugs of this group.Imipenem 1. Unique pharmacologic problem: After imipenem is removed from the circulation by glomerular filtration and secreted, it is metabolized by a renal peptidase which is located on the brush border of the proximal renal tubules. The metabolites are nephrotoxic. 2. To overcome this problem, a specific peptidase inhibitor, cilastin, was synthesized, which totally blocks the metabolism of imipenem in the kidney, thus blocking toxicity. Cilastin has no antimicrobial activity. 3. Compound drug is imipenem-cilastin combination (Primaxin). 4. Particular toxicity is seizures, primarily in renal failure or in the face of ongoing or preceding brain injury.
Other Inhibitors of Cell-Wall SynthesisVancomycinVancomycin, a glycopeptide, is active only against gram-positive bacteria, including ß-lactamase producing staphylococci and those resistant to nafcillin and methicillin Vacomycin is an inhibitor of bacterial cell wall synthesis by preventing peptidoglycan elongation and cross-linking. The resistance to the antibacterial action of vancomycin is due to a modification of its peptidoglycan binding site, a modification that reduces binding affinity. Vancomycin acts synergistically with gentamicin and streptomycin (aminoglycosides) against E. faecium and E. faecalis isolates not resistant to aminoglycosides.Vancomycin is not absorbed after oral administration. Slow I.V infusion is employed for treatment of systemic infections or prophylaxis. Oral administration, is only employed for the treatment of antibiotic induced colitis due to Closteridium difficile when metronidazole has proven ineffective. Major Clinical Use Sepsis Endocarditis due to methicillin resistant staphylococci Methicillin-susceptible Staph isolates would be more effectively treated with methicillin than vancomycin. Treatment alternative enterococcal endocarditis.: Vancomycin with gentamycin: for patient allergic to penicillin. Vancomycin incombination with cefotaxime, ceftriaxone or rifampim: appropriate for treatment of mennigitis when the suspected infecting agent is thought/known to be highly penicillin resistant. Adverse effect: Fever and chills Phlebitis at the infusion site. Flushing and shock results from histamine release. Dose related hearing loss has occurred in patients with renal failure. Ototoxicity more common when vancomycin is administered with another drug that can also produce these effects.
Protein synthesis inhibitors: Aminoglycosides-The aminoglycosides include streptomycin, neomycin, kanamycin, amikacin, gentamicin, tobramycin, sisomicin, netilmicin, and others. Structure—All aminoglycosides consist of central six-membered aminocyclitol ring linked to two or more aminosugar residues by glycosidic bonds. Mechanism of ActionAminoglycosides are irreversible inhibitors of protein synthesis, but the precise mechanism for bactericidal activity is not known. The initial event is passive diffusion via porin channelsacross the outer membrane. Inside the cell, aminoglycosides bind to specific 30S-subunitribosomal proteins. Protein synthesis is inhibited by aminoglycosides in at least three ways (1) interference with the initiation complex of peptide formation; (2) misreading of mRNA, which causes incorporation of incorrect amino acids into the peptide and results in a nonfunctional or toxic protein (3) breakup of polysomes into nonfunctional monosomes. These activities occur more or less simultaneously, and the overall effect is irreversible and lethal for the cell.
Spectrum of Activity and clinical uses:Clinical Uses- Aminoglycosides are mostly used against gram-negative enteric bacteria [Klebsiella species: an aminoglycoside (gentamicin + an antipseudomonal penicillin), Yersinia pestis, Francisella tularensis, and brucella species (gentamicin or streptomycin + doxycycline). Pseudomonas aeuroginosa: infections in immunocompromised patients and in burn victims: (tobramycin + anti-pseudomonal penicillin)].- Streptomycin is used for tuberculosis.- Aminoglycosides used in combination with a β-lactam antibiotic to extend coverage to include potential gram-positive pathogens and to take advantage of the synergism between these two classes of drugs. -Penicillin+aminoglycoside combinations also are used to achieve bactericidal activity in treatment of enterococcal endocarditis and to shorten duration of therapy for viridans streptococcal and some patients with staphylococcal endocarditis.
Mechanisms of ResistanceThree principal mechanisms have been established: (1) production of a transferase enzyme or other enzymes inactivates the aminoglycoside by adenylylation, acetylation, or phosphorylation. (2) There is impaired entry of aminoglycoside into the cell. (3) The receptor protein on the 30S ribosomal subunit may be deleted or altered by mutation.
PharmacokineticsAminoglycosides are absorbed very poorly from the intact gastrointestinal tract, and almost the entire oral dose is excreted in feces after oral administration. However, the drugs may be absorbed if ulcerations are present. After intramuscular injection, aminoglycosides are well absorbed, giving peak concentrations in blood within 30–90 minutes. Aminoglycosides are usually administered intravenously as a 30- to 60-minute infusion; after a brief distribution phase, this results in serum concentrations that are identical with those following intramuscular injection. The normal half-life of aminoglycosides in serum is 2–3 hours, increasing to 24–48 hours in patients with significant impairment of renal function. Even after parenteral administration, concentrations of aminoglycosides are not high in most tissues. They are poorly penetrated CNS, in the presence of active inflammation, however, cerebrospinal fluid levels reach 20% of plasma levels, and in neonatal meningitis, the levels may be higher. Intrathecal injection is required for high levels in cerebrospinal fluid. All aminoglycosides are rapidly excreted into the urine, predominantly by glomerular filtration. Accumulation occurs in patients with renal impairment, it requires dose modification. -All aminoglycosides are ototoxic and nephrotoxic. Ototoxicity and nephrotoxicity are more likely to be encountered when therapy is continued for more than 5 days, at higher doses, in the elderly, and in the setting of renal insufficiency. Concurrent use with loop diuretics (eg, furosemide, ethacrynic acid) or other nephrotoxic antimicrobial agents (eg, vancomycin or amphotericin) can potentiate nephrotoxicity and should be avoided if possible. Ototoxicity can manifest either as auditory damage, resulting in tinnitus and high-frequency hearing loss initially, or as vestibular damage, evident by vertigo, ataxia, and loss of balance. -Nephrotoxicity results in rising serum creatinine levels or reduced creatinine clearance, although the earliest indication often is an increase in trough serum aminoglycoside concentrations. Neomycin, kanamycin, and amikacin are the most ototoxic agents. Streptomycin and gentamicin are the most vestibulotoxic. Neomycin, tobramycin, and gentamicin are the most nephrotoxic. -In very high doses, aminoglycosides can produce a curare like effect with neuromuscular blockade that results in respiratory paralysis. This paralysis is usually reversible by calcium gluconate (given promptly) or neostigmine. -Hypersensitivity occurs infrequently.
StreptomycinStreptomycin was isolated from a strain of Streptomyces griseus. Clinical Uses Mycobacterial Infections:Streptomycin is mainly used as a second-line agent for treatment of tuberculosis. The dosage is 0.5–1 g/d (7.5–15 mg/kg/d for children), which is given intramuscularly or intravenously. It should be used only in combination with other agents to prevent emergence of resistance. Nontuberculous Infections:In plague, tularemia, and sometimes brucellosis, streptomycin, 1 g/d (15 mg/kg/d for children), is given intramuscularly in combination with an oral tetracycline.Penicillin plus streptomycin is effective for enterococcal endocarditis and 2-week therapy of viridans streptococcal endocarditis.Gentamicin has largely replaced streptomycin for these indications.Streptomycin remains a useful agent for treating enterococcal infections, however, because approximately 15% of enterococcal isolates that are resistant to gentamicin (and therefore resistant to netilmicin, tobramycin, and amikacin) will be susceptible to streptomycin.Adverse ReactionsFever, skin rashes, and other allergic manifestations may result from hypersensitivity to streptomycin. This occurs most frequently with prolonged contact with the drug either in patientswho receive a prolonged course of treatment (eg, for tuberculosis). Pain at the injection site is common but usually not severe. The most serious toxic effect with streptomycin is disturbance of vestibular function-vertigo and loss of balance. Vestibular toxicity tends to be irreversible. Streptomycin given during pregnancy can cause deafness in the newborn and, therefore, is relatively contraindicated.
GentamicinGentamicin is isolated from Micromonospora purpurea . It is effective against both gram-positive and gram-negative organisms.C1a component of gentamicin.Antimicrobial ActivityGentamicin sulfate, 2–10 mcg/mL, inhibits in vitro many strains of staphylococci and coliforms and other gram-negative bacteria. It is active alone, but also as a synergistic companion with β-lactam antibiotics, against Escherichia coli , Proteus , Klebsiella pneumoniae, Enterobacter, Serratia , Stenotrophomonas , and other gram-negative rods that may be resistant to multiple other antibiotics. Like all aminoglycosides, it has no activity against anaerobes.Clinical UsesIntramuscular or Intravenous AdministrationGentamicin is used mainly in severe infections (eg, sepsis and pneumonia) caused by gram-negative bacteria that are likely to be resistant to other drugs, especially P aeruginosa , Enterobacter sp, Serratia marcescens , Proteus sp, Acinetobacter sp, and Klebsiella sp.It usually is used in combination with a second agent because an aminoglycoside alone may not be effective for infections outside the urinary tract. For example, gentamicin should not be used as a single agent to treat staphylococcal infections because resistance develops rapidly. Aminoglycosides also should not be used for single-agent therapy of pneumonia because penetration of infected lung tissue is poor and local conditions of low pH and low oxygentension contribute to poor activity. Gentamicin 5–6 mg/kg/d traditionally is given intravenously in three equal doses, but once daily administration is just as effective for some organisms and less toxic.Gentamicin, in combination with a cell wall-active antibiotic, is also indicated in the treatment of endocarditis caused by grampositive bacteria (streptococci, staphylococci, and enterococci).The synergistic killing achieved by combination therapy may achieve bactericidal activity necessary for cure or allow for the shortening of the duration of therapy. The doses of gentamicin used for synergy against gram-positive bacteria are lower than traditional doses. Typically the drug is administered at a dose of 3 mg/kg/day in three divided doses. Peak levels should be approximately 3 mcg/mL, while trough levels should be < 1 mcg/mL. There are limited data to support administering the 3-mg/kg dose as a single daily injection in the treatment of streptococcal endocarditis.Topical and Ocular AdministrationCreams, ointments, and solutions containing 0.1–0.3% gentamicin sulfate have been used for the treatment of infected burns, wounds, or skin lesions and in attempts to prevent intravenouscatheter infections. Intrathecal AdministrationMeningitis caused by gram-negative bacteria has been treated by the intrathecal injection of gentamicin sulfate, 1–10 mg/d.Adverse ReactionsNephrotoxicity is usually reversible and mild. It occurs in 5–25% of patients receiving gentamicin for longer than 3–5 days Ototoxicity, which tends to be irreversible, manifests itself mainly as vestibular dysfunction.Occurs in 1–5% patient receiving gentamicin for more than 5 days. Hypersensitivity reactions to gentamicin are uncommon.
TobramycinTobramycin has almost the same antibacterial spectrum as gentamicin with a few exceptions. Gentamicin is slightly more active against S marcescens , whereas tobramycin is slightly moreactive against P aeruginosa ; Enterococcus faecalis is susceptible to both gentamicin and tobramycin, but E faecium is resistant to tobramycin. Kinetic and side effects, like gentamicin AmikacinAmikacin is a semisynthetic derivative of kanamycin; it is less toxic than the parent molecule. It is resistant to many enzymes that inactivate gentamicin and tobramycin, and it thereforecan be used against some microorganisms resistant to the latter drugs. Many gram-negative bacteria, including many strains of Proteus , Pseudomonas , Enterobacter , and Serratia , are sensitive. NetilmicinNetilmicin shares many characteristics with gentamicin and tobramycin, netilmicin may be active against some gentamicin-resistant and tobramycin-resistant bacteria. Dose and side effects are similar to gentamicin.Neomycin and kanamycinNeomycin and kanamycin are closely related. Neomycin and kanamycin are now limited to topical and oral use. Neomycin is too toxic for parenteral use. Parenteral administration of kanamycin has also been largely abandoned. In preparation for elective bowel surgery, 1 g of neomycin is given orally every 6–8 hours for 1–2 days, often combined with 1 g of erythromycin base. This reduces the aerobic bowel flora with little effect on anaerobes.Paromomycin Paromomycin has recently been shown to be effective against visceral leishmaniasis when given parenterally.Spectinomycin Spectinomycin is no longer available for useIt is active in vitro against many gram-positive and gram-negative organisms, but it is used almost solely as an alternative treatment for drug-resistant gonorrhea or gonorrhea inpenicillin-allergic patients.